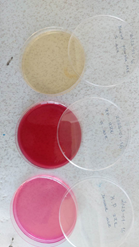

Монгол орны хэмжээнд шүлхий, бог малын мялзан өвчний халдварлалтын түвшин, тархалтын түвшинг тогтоох үндсэн зорилгын хүрээнд Мал эмнэлгийн ерөнхий газрын даргын 2024 оны 05 дугаар сарын 06-ны өдрийн “Малын гоц халдварт өвчний тандалт зохион байгуулах тухай” А/152 дугаар тушаал, тушаалын 1 дүгээр хавсралт буюу Мал, амьтны гоц халдварт шүлхий, бог малын мялзан өвчний ийлдэс судлалын тандалтын удирдамжийн дагуу хэрэгжилтийг ханган Дундговь аймгийн мал сүрэгт 2024 оны 05-р сарын 24-нөөс 05 сарын 31-ний өдрүүдэд Аймгийн хэмжээнд санамсаргүй сонголтын аргаар нийт 9766 малчин, мал бүхий өрхөөс 30 малчин өрхийг сонгон тандалт шинжилгээнд хамруулсан. Тандалтанд санамсаргүй сонголтын аргаар 14 сумын 30 малчин өрхийн ямаа 180, хонь 180, үхэр 120 нийт 480 малаас дээж цуглуулан ажиллаа. Тандалт шинжилгээний сорьц цуглуулах ажлыг Мал эмнэлгийн лаборатори удирдлага зохион байгуулалтаар хангаж, аймгийн Мал эмнэлгийн лабораторийн шинжээч эмч нар болон 12 сумын МЭ-ийн тасгийн тархвар зүйч, улсын байцаагч, МЭҮН-ийн эмч, жолоочийн хамт түргэн шуурхай хийж гүйцэтгэсэн. Сорьц цуглуулах ажлын явцад малын бүртгэл хөтлөн ийлдсийг ялган тэмдэглэж, “ТАНДАЛТЫН СИСТЕМ”-д малчдаас асуумж, малын бүртгэлийн мэдээллийг бөглөж сүлжээгээр илгээж удирдамжийн дагуу ажилласан.



Аймгийн Мал эмнэлгийн газрын нөөцөд тулгуурлан 1 удаагийн зүү, вакумт хуруу шил, зүү баригч, шинжилгээний урвалж, хавтан соруурын хошуу, бусад хэрэглэгдэхүүнийг ашиглан 1 сорьцонд 1 хэрэгсэл зарчмаар хэрэгжүүлсэн. Цусны ийлдсийг хээрийн нөхцөлд ялган машины хөргөгчинд хадгалан аймгийн МЭЛабораторит хүргүүлсэн. Шинжилгээнд ашигласан автомат соруурын хошуу, хавтан бусад хэрэглэгдэхүүнийг ашиглан зохих журмын дагуу устгасан болно.

Шинжилгээний ажлыг 2024 оны 06 дугаар сарын 04-ны өдөр аймгийн Мал эмнэлгийн лабораторийн ийлдэс судлалын лабораторит Ийлдэс, шимэгч судлалын шинжээч их эмч Н.Балданжав, ариун цэвэр магадлан шинжилгээний шинжээч их эмч Д.Бурмаа нар хийж гүйцэтгэж байна.